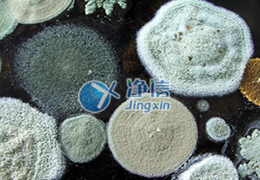

Home
News

2020.12.21
凈信組織研磨儀|研磨大鼠肝臟做藥物殘留檢測
上海凈信全自動組織研磨儀是一種特殊的、快速的、高效率的、多試管的一致系統。它能將任何來源(包括土壤、植物和動物的組織/器官、細菌、酵母、真菌、孢子、古生物標本等)的原始DNA、RNA和蛋白質進行提取和純化。

2020.12.21
病毒變異貂傳人|凈信研磨儀持續為新冠病毒研究服務
新型冠狀病毒引起的全球大流行,已累積感染超過4800萬人,導致了超過120人死亡,而且,這一數字仍在快速增加中,隨著北半球冬季的到來,疫情二次爆發也隨之而來。

2020.12.21
誠邀|凈信11月展會,不光“有料”還有好禮!
為回饋新老客戶,助力科研抗疫,凈信在展會期間特推出“買就送”活動,具體活動內容請詳詢現場工作人員!

2020.12.21
凈信組織研磨儀在整合素調控調節性T細胞新機制中的應用
上海凈信依托強大的研發和生產服務能力,多年來已成功為數萬個實驗室提供服務。目前已經在國內外雜志上發表相關論文達1300多篇,其中幾百篇發表在高水平SCI雜志上。凈信到目前為止已經擁有五代研磨儀產品,隨著科研的進步和技術革命的改變,凈信一直會緊跟腳步不斷對現有的產品進行技術改善,并創造出更多新的產品,以期更好的為廣大科研工作者服務!
2020.12.21
凈信高通量組織研磨儀|食品真菌毒素檢測
高通量組織研磨儀采用三維一體8字形振蕩方式,研磨更充分,穩定性更好;在研磨過程中處于全封閉狀態,樣品無交叉污染,大大提高的樣品前處理的效率!

2020.12.21
上海凈信:淺談秋冬季非洲豬瘟如何防控
又到了秋冬季非洲豬瘟重點防控的時間了!從9月中下旬,德國、越南等國家相繼報告了非洲豬瘟病例,近日前重慶也排查出了非洲豬瘟,引起廣泛關注。非洲豬瘟發生于非洲已有百年之久,是世界范圍內危害養豬業的“頭號殺手”。

2020.12.21
上海凈信2020年第三季度銷售工作總結會議
人們總用金秋來訴說十月,金秋是收獲的季節。在凈信任眼中,十月,是一年里,值得讓我們思考的月份。10.17-18,上海凈信各區銷售代表、工廠(松江/昆山/江山)、電商部門代表齊聚一堂,認真總結第三季度工作落實情況、問題反饋、分析討論,以及全面部署四季度沖刺全年的各項工作。

2020.12.21
上海凈信多樣品組織研磨機研磨海底珊瑚
多樣品組織研磨機與目前已有的其它樣品制備方法相比,具有通用性廣、高效靈活的優點。該系統避免了研磨、勻漿、超聲波處理等傳統方法的費力、耗時、低效等諸多缺點,可以高效、快速、穩定地裂解并純化各種類型樣品的核酸與蛋白。

2020.12.21
上海凈信播報:專家確認全球二次疫情已開始
假期剛過,青島就發生疫情了,令人措不及防。據青島市衛健委12日通報稱,青島市新增核酸檢測結果陽性9人。其中4例為確診病例、5例為無癥狀感染者。青島市政府要求,全市所有人都需做核酸檢測,青島全市常住人口超過939萬,檢測規模和難度可想而知。而且,檢測需要時間,交叉感染速度卻很快,這確實又是一次重大考驗。

2020.12.21
科研人在實驗室都做些什么?凈信組織研磨儀來解密~
上海凈信是中國多樣品組織研磨儀及冷凍研磨儀創新者!?凈信研發的"Tissuelyser系列多樣品組織研磨機“和”JXFSTPRP系列三維運動的全自動樣品快速研磨機"、“三維離心冷凍研磨儀”、“超聲波超細篩分”、“液氮冷凍研磨儀”、土壤研磨機、高能研磨機、臼式研磨機、鄂式破碎儀、葉綠素a研磨儀、超聲波破碎儀、3D混勻儀、智能勻漿機等產品一直被國家重點實驗室所青睞和廣泛采用。

2020.12.21
DNA、RNA和蛋白質提取和純化,如何提供全面保護?
凈信冷凍研磨儀能將任何來源樣品的原始DNA、RNA和蛋白質進行提取和純化,低溫研磨樣品能夠有效抑制核酸降解、保留蛋白質活性,減少樣品的揮發,更完整保留樣品成分含量。藥物有效成分的異構體之間常常存在重大區別,低溫研磨可預防分子因壓力和受熱而降解。對于高韌塑料、高強塑料、樹脂等難研磨樣品,低溫研磨可大大提高研磨效果及效率。在國內很多高校和科研機構都獲得不錯的口碑!

2020.12.21
凈信快速組織破碎儀研磨頭發(干磨&濕磨)
凈信Tissue-prp系列快速組織破碎儀是一款比較好的選擇,因其毛發頭發本身質地松軟且體積細小,常規的研磨方法和儀器是很難完成實現的,而且大的儀器也不方便攜帶到外面操作。該研磨儀器使用獨特的創新設計,成為市場上體積比較小、使用很方便、通用性強的高通量組織細胞破碎儀。

2020.12.21
不得不解的“固廢難題”!
常規的固廢處理方法有填埋、焚燒,但填埋和焚燒都有不同程度的缺點和危害?,F在的固體廢棄物的處理已經得到廣泛的關注,與國外的發展技術相比還是有很多的不足。科研人員也在不斷發展創新技術,上海凈信也會一直努力為廣大科研工作者提供服務!

2020.12.21
水質環境監測之水體富營養化-新型組織研磨儀
湖泊水體富營養化是當今世界面臨的最主要的水污染問題,而在環境監測中,葉綠素a含量是評價水體富營養化的指標之一。凈信新型組織研磨儀JXFSTPRP-YLS三維一體震蕩模式,使得樣品研磨更加均勻、充分,樣品重復性好,樣品之間沒有交叉污染,是真正的高通量研磨振蕩系統。

2020.12.21
凈信球磨儀應用:環境監測領域之土壤
檢測土壤重金屬的第一步也是樣品前處理的問題,它直接關系著后續實驗的成敗。上海凈信JX-4G高性能球磨儀可以在短時間內將樣品研磨至納米級別,適合對軟性、中硬性、極硬性、脆性樣品進行研磨(干磨或濕磨)及混合處理,并且保證研磨結果具有可重復性。能應用在理化分析前處理、膠體研磨、新型材料和機械合金的制備等方面。







